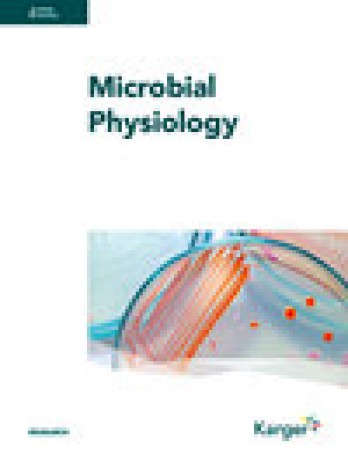

《Microbial Physiology》的主要研究方向:Multiple。
期刊特色:
《Microbial Physiology》作為一本專注于Multiple的國際期刊,通過發(fā)表高質(zhì)量的綜述文章,為研究人員和學(xué)生提供了深入了解該領(lǐng)域最新研究進展的機會。該期刊反映了Multiple的前沿動態(tài)。期刊彌合了最新研究與傳統(tǒng)教科書之間的差距,幫助讀者了解進入該領(lǐng)域所需的基本知識。這不僅推動了學(xué)術(shù)交流,還為相關(guān)領(lǐng)域的研究提供了重要的參考,促進了該領(lǐng)域科研交流和科研成果轉(zhuǎn)化。
期刊影響力:
該期刊的影響因子為2.9。
中科院分區(qū)信息在大類學(xué)科中生物學(xué)為:4區(qū),小類學(xué)科中BIOTECHNOLOGY & APPLIED MICROBIOLOGYMultiple:4區(qū),
中科院分區(qū)信息
微生物生理學(xué)2023年12月升級版
| 大類學(xué)科 | 分區(qū) | 小類學(xué)科 | 分區(qū) | Top期刊 | 綜述期刊 |
| 生物學(xué) | 4區(qū) |
BIOTECHNOLOGY & APPLIED MICROBIOLOGY
生物工程與應(yīng)用微生物
MICROBIOLOGY
微生物學(xué)
|
4區(qū)
4區(qū)
|
否 | 否 |
微生物生理學(xué)2022年12月升級版
| 大類學(xué)科 | 分區(qū) | 小類學(xué)科 | 分區(qū) | Top期刊 | 綜述期刊 |
| 生物學(xué) | 4區(qū) |
BIOTECHNOLOGY & APPLIED MICROBIOLOGY
生物工程與應(yīng)用微生物
MICROBIOLOGY
微生物學(xué)
|
4區(qū)
4區(qū)
|
否 | 否 |
中科院JCR期刊分區(qū)(又稱分區(qū)表、分區(qū)數(shù)據(jù))是中國科學(xué)院文獻情報中心世界科學(xué)前沿分析中心的科學(xué)研究成果。在中科院期刊分區(qū)表中,主要參考3年平均IF作為學(xué)術(shù)影響力,最終每個分區(qū)的期刊累積學(xué)術(shù)影響力是相同的,各區(qū)的期刊數(shù)量由高到底呈金字塔式分布。
JCR分區(qū)信息:
按JIF指標(biāo)學(xué)科分區(qū):Q2,按JCI指標(biāo)學(xué)科分區(qū):Q3
JCR分區(qū)信息
Microbial Physiology(2023-2024年最新版數(shù)據(jù))
| 按JIF指標(biāo)學(xué)科分區(qū) | 收錄子集 | 分區(qū) | 排名 | 百分位 |
| 學(xué)科:BIOTECHNOLOGY & APPLIED MICROBIOLOGY | SCIE | Q2 | 86 / 174 |
50.9%
|
| 學(xué)科:MICROBIOLOGY | SCIE | Q3 | 83 / 161 |
48.8%
|
| 按JCI指標(biāo)學(xué)科分區(qū) | 收錄子集 | 分區(qū) | 排名 | 百分位 |
| 學(xué)科:BIOTECHNOLOGY & APPLIED MICROBIOLOGY | SCIE | Q3 | 130 / 174 |
25.57%
|
| 學(xué)科:MICROBIOLOGY | SCIE | Q4 | 122 / 161 |
24.53%
|
湯森路透每年出版一本《期刊引用報告》(Journal Citation Reports,簡稱JCR)。JCR對86000多種SCI期刊的影響因子(Impact Factor)等指數(shù)加以統(tǒng)計。JCR將收錄期刊分為176個不同學(xué)科類別在JCR的Journal Ranking中,主要參考當(dāng)年IF,最終每個分區(qū)的期刊數(shù)量是均分的。
(4)CiteScore:5.2,SJR:0.698,SNIP:0.815。
Cite Score(2024年最新版)
- CiteScore:5.2
- SJR:0.698
- SNIP:0.815
| 學(xué)科類別 | 分區(qū) | 排名 | 百分位 |
| 大類:Biochemistry, Genetics and Molecular Biology 小類:Biotechnology | Q2 | 138 / 311 |
55%
|
| 大類:Biochemistry, Genetics and Molecular Biology 小類:Physiology | Q2 | 89 / 193 |
54%
|
| 大類:Biochemistry, Genetics and Molecular Biology 小類:Applied Microbiology and Biotechnology | Q2 | 62 / 127 |
51%
|
| 大類:Biochemistry, Genetics and Molecular Biology 小類:Microbiology | Q3 | 95 / 182 |
48%
|
| 大類:Biochemistry, Genetics and Molecular Biology 小類:Biochemistry | Q3 | 231 / 438 |
47%
|
| 大類:Biochemistry, Genetics and Molecular Biology 小類:Cell Biology | Q3 | 185 / 285 |
35%
|
CiteScore:該指標(biāo)由Elsevier于2016年提出,指期刊發(fā)表的單篇文章平均被引用次數(shù)。CiteScorer的計算方式是:例如,某期刊2022年CiteScore的計算方法是該期刊在2019年、2020年和2021年發(fā)表的文章在2022年獲得的被引次數(shù),除以該期刊2019年、2020年和2021發(fā)表并收錄于Scopus中的文章數(shù)量總和。
聲明:本信息依據(jù)互聯(lián)網(wǎng)公開資料整理,若存在錯誤,請及時聯(lián)系我們及時更正。